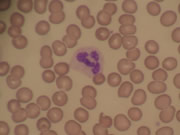

中央検査科
特色
気の診断や治療のための臨床検査を行っています。
内部精度管理、外部精度管理を行い、より正確な検査結果を報告するよう心がけています。
また、夜間・祝日24時間緊急対応を行っています。
取得認定資格
- 超音波検査士(循環器、血管、消化器、泌尿器、体表臓器)
- 緊急臨床検査士
- 二級臨床検査士
検体検査
中央検査科では検体検査と生理機能検査でそれぞれ分かれて検査を行っています。まずは検体検査について紹介します。
検体検査では体内を流れる血液、尿などの分析を行い、診察に必要な情報を報告しています。
生化学

人間の体は蛋白質、脂質、ミネラルなど多くの物質がバランスよく構成されて健康を保つことができます。
体調が悪くなるとそのバランスが崩れるため、これらを血液から分析することによって多くの情報を得ることができます。
免疫
細菌やウイルス(抗原)が体に侵入すると、戦うために抗体が造られ攻撃します。
この抗原と抗体をしらべる感染症の検査や、悪性腫瘍細胞の補助診断や治療効果に用いられる腫瘍マーカー、またホルモン検査なども行っています。
血液
血液中の細胞は
- 体中にO2を運んでいる赤血球
- 異物が外から入ってきたときに反応する白血球
- 出血を止める血小板
の3つからなっています。
この3つの細胞の量や形に異常がないか検査しています。
凝固
血小板と共に出血を止める物質が血液中にはたくさん含まれています。
この物質がしっかり働いているか調べているのが凝固検査です。
一般
一般検査とは患者さんから採取した血液以外の材料の検査のことで、主に尿、胸水、腹水、髄液などの材料となります。
尿

血液中の不要になった物質を腎臓でろ過し、できたものが尿となります。
様々な病気によってこの尿中に本来含まれてないものがはいっていることがあり、その有無を検査しています。
また、尿中には腎臓や膀胱の細胞が含まれているため、腎臓や膀胱そのものの状態をみることもできます。
髄液
脳や脊髄を覆っている液体を髄液といいます。
髄液の中の細胞数やミネラルを検査することで、髄膜炎などを調べることができます。
胸水、腹水
胸水、腹水とは何らかの病気によってお腹や胸に溜まってしまった水のことです。
この水の成分を検査することで原因となっている病気が何か調べることができます。
輸血検査
輸血をする際に必要な血液型を調べ、安全に輸血が行えるように血液製剤が使用する患者さんに適合しているか検査しています。
抗酸菌
喀痰中に抗酸菌と呼ばれる菌がいないか検査します。
この抗酸菌という種類の菌の中には結核を引き起こす結核菌という菌がいるので、結核の診断に重要な検査です。
睡眠時無呼吸の検査
睡眠時無呼吸症候群とは睡眠時に呼吸が止まり、日常生活に様々な障害を引き起こす疾患です。
入院中や自宅に持ち帰ってできる睡眠時無呼吸検査(SAS)は、指や腹などにセンサーを着け血中の酸素や呼吸状態を見る検査です。
また、脳波、眼球運動、呼吸状態、心電図、下肢の動き、血中の酸素などを見るポリソムノグラフィー(PSG)は、入院していただいて行う検査です。
さらに、指にセンサーを着けて心拍と血液の酸素飽和度を測定する終夜経皮的酸素飽和度検査があります。
聴力検査
耳の聞こえが悪いとき、どの位の大きさの音まで聞こえているのか、どのような高さの音が聞こえづらくなっているのかを検査しています。
生理検査
生理検査では患者さんと接しながら検査を行っています。
心電図検査
心臓は収縮・拡張を繰り返して全身に血液を送るポンプの役割をしています。
その収縮・拡張の前に心臓の筋肉は電気的に興奮したり、さめたりして微小な電気が現れます。
その電気信号を記録しているのが心電図です。
- 不整脈が現れているか?
- 高血圧性変化がでているか?
- 狭心症や虚血性変化が現れているか?
- 各種手術前に心配な心臓疾患は無いか?
などをみています。
運動負荷心電図検査(約30分)

安静時の心電図を記録し、その後心電図と血圧を記録しながら動くベルトの上で運動をしていただきます。
運動終了後も負荷後の心電図、血圧を記録していきます。
主に体を動かしたときに胸痛などの症状が出現する労作性狭心症の診断や、心筋梗塞後のリハビリテーションを進めていくための運動耐容量を決めるとき、運動により誘発される不整脈の診断などに用いられます。
ホルター心電図検査
日常生活の中での心電図波形を24時間にわたり連続で記録します。記録中の心電図のリズム変化と虚血による波形の変化がわかります。外来で胸痛等の自覚症状を訴える方の多くは、受診時の心電図に変化がみられないことが多くこのような症状を解明する手がかりになります。
心肺運動負荷試験( Cardio pulmonary exercise test : CPX )
当院ではエルゴメータという自転車型の装置を用いて運動負荷試験を行っています。心電図・血圧・血中酸素濃度および呼気ガス文責により呼吸・循環・代謝指標を測定するものです。
この検査により、労作時息切れや動悸の鑑別、各種心疾患、心不全の重傷度や治療効果判定、運動療法、心臓リハビリテーションの運動処方作成に必要な指標が得られます。
超音波検査

心臓超音波検査(約30分)
超音波(非常に高い周波数の音波)を利用して、心臓の各部位の形や大きさの異常、動きの異常などを評価します。
心臓病の診断や重症度の評価、心筋梗塞や弁の障害の評価に役立ちます。
頸動脈超音波検査(約30分)
頸動脈は脳へ血液を送る重要な血管です。
頸動脈の状態から全身の動脈硬化の進行具合を推定できるため、脳梗塞のほか生活習慣病、メタボリックシンドローム、狭心症、心筋梗塞などの疾患の早期発見に有用です。
超音波により血管の太さ、血管壁の厚さ、血管の狭窄等を調べます。
下肢血管超音波検査(約1時間)
動脈:歩行時の足のしびれや痛みの原因となる血管の狭窄や閉塞を調べます。
静脈:エコノミー症候群を引き起こす深部静脈血栓症や、静脈瘤を調べます
腹部超音波検査(約20分)
肝臓、胆嚢、膵臓、脾臓、腎臓などの大きさや形に異常がないかどうかを調べます。
例えば胆石・腎結石の有無や各臓器の病変の有無を調べるために検査をします。
表在組織超音波検査(約20分)
甲状腺、頚部、乳腺や体の表面にできたしこりなどの大きさや形などを調べます。
ABI/CAVI検査
ABI(足首/上腕血圧比)は血管のつまり具合の指標で、閉塞性動脈硬化性の診断に使われます。
CAVI(心臓足首血管指数)は血管の硬さの指標で動脈硬化の進み具合がわかります。
ベッド上で血圧計を両腕・両足に装着し5分ほど安静にしていただく簡単な検査です。
肺機能検査
呼吸機能の基本的な検査として、肺がどのくらい膨らむことができるか、息を吐き出すのに負担はないかどうかを調べます。
肺の換気状態を知ることで、手術時の肺合併症を防ぐために必要な検査です。
神経機能検査
糖尿病合併症の中で最も早くから出現し、頻度が高いことが知られている糖尿病性神経障害のほか手根管症候群、肘部管症候群などの神経障害の有無や程度、部位の評価に役立ちます。
- 自律神経検査
- 振動覚検査
- 運動神経伝導速度
手足の神経をごく弱い電気で刺激し、末梢神経に伝わる速度を測定します。
脳波検査(約1時間30分)
脳が働いているときは微小な電気が発生しています。
その電気活動を捉えたものが脳波検査です。
てんかんや脳腫瘍、脳虚血発作などの診療において重要な検査であり、脳の機能に異常があるかないかを調べます。


